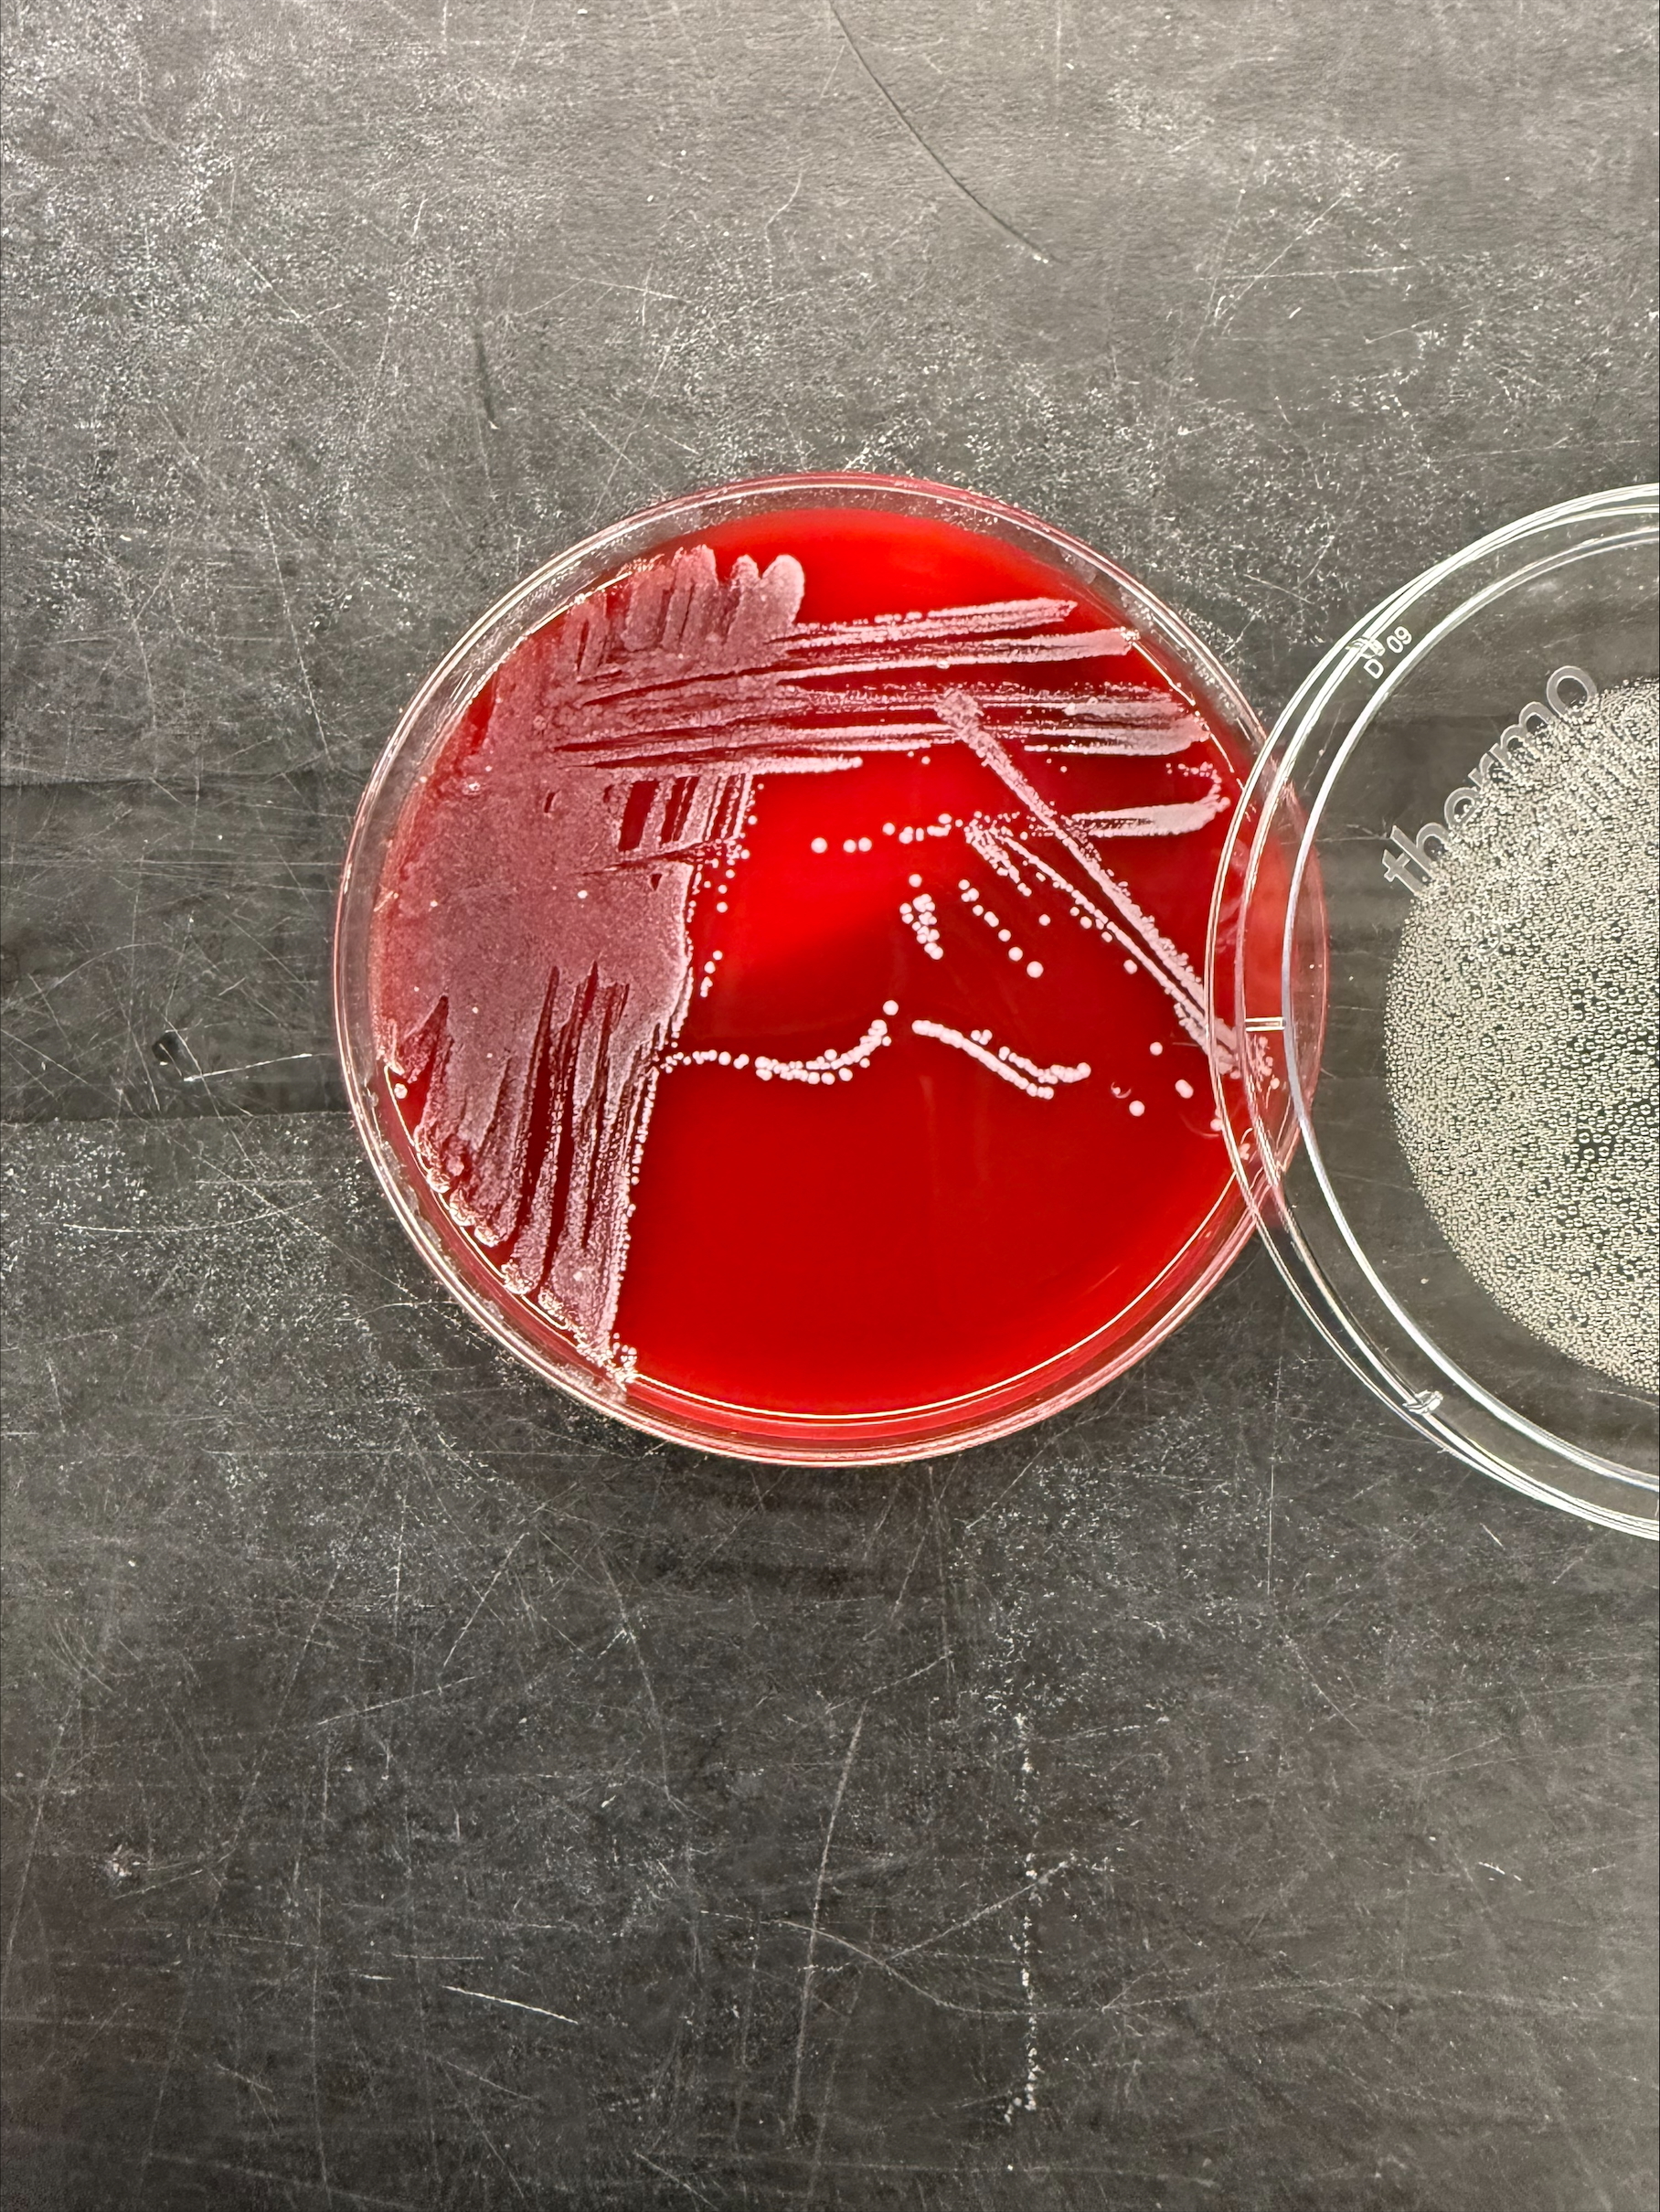
4363438_File000002.jpg

Final ID: MP81
My Heart Will Go On: A Rare Case of Massive Candida Auris Pericardial Effusion
Abstract Body (Do not enter title and authors here): A 40-year-old male with past medical history of Methicillin-resistant staphylococcus aureus endocarditis treated with open valve replacement of tricuspid valve and resection of aortic valve vegetation, history of deep vein thrombosis with Inferior Vena Cava filter placement, history of IV drug use, acute cholecystitis requiring percutaneous cholecystostomy tube placement, type 2 diabetes mellitus on chronic insulin therapy, hypertension, hyperlipidemia, degenerative spine disease who presents to an urgent care facility due to hallucinations. At the urgent care facility, imaging showed a pericardial effusion for which he was sent to our hospital. A CT chest without contrast on admission showed a large pericardial effusion, redemonstrated on transthoracic echocardiogram. Patient underwent subxiphoid pericardial window creation with pericardial drain placement with cardiothoracic surgery, draining a total of 2265ml of murky yellow fluid over 7 days. Pericardial fluid grew Candida Auris, for which the patient was treated with 10 days of intravenous micafungin initiated on admission day 6.
Candida auris has been recognized to cause a wide range of infections, with pericarditis being an infrequent occurrence. Fungal pericarditis is an uncommon infection, with a reported prevalence of 1.4% based on one review, which makes Candida pericarditis with pericardial effusion even rarer. Like our patient, 50% are immunocompetent and only 50% present with classical symptoms of chest pain, fever, and dyspnea. These factors contribute significantly to diagnostic delay, with fungal pericarditis accurately recognized in only 15.8% of cases within 48 hours of presentation, with empiric treatment initiated in 35.6% of cases within 48 hours. The mortality rate associated with Candida or fungal pericarditis is 50%, and the timely initiation of antifungal treatment has demonstrated a statistically significant improvement in patient survival(p = 0.0011). IV echinocandins are first-line treatment for suspected invasive candidiasis in non-neutropenic patients. There is low-quality evidence regarding the duration of antifungal treatment, however, the latest 2016 Infectious Disease Society of America update on Candida infections recommends two weeks of treatment. This is a grey area that requires clinical trials to establish evidence-based guidelines.
Candida auris has been recognized to cause a wide range of infections, with pericarditis being an infrequent occurrence. Fungal pericarditis is an uncommon infection, with a reported prevalence of 1.4% based on one review, which makes Candida pericarditis with pericardial effusion even rarer. Like our patient, 50% are immunocompetent and only 50% present with classical symptoms of chest pain, fever, and dyspnea. These factors contribute significantly to diagnostic delay, with fungal pericarditis accurately recognized in only 15.8% of cases within 48 hours of presentation, with empiric treatment initiated in 35.6% of cases within 48 hours. The mortality rate associated with Candida or fungal pericarditis is 50%, and the timely initiation of antifungal treatment has demonstrated a statistically significant improvement in patient survival(p = 0.0011). IV echinocandins are first-line treatment for suspected invasive candidiasis in non-neutropenic patients. There is low-quality evidence regarding the duration of antifungal treatment, however, the latest 2016 Infectious Disease Society of America update on Candida infections recommends two weeks of treatment. This is a grey area that requires clinical trials to establish evidence-based guidelines.
More abstracts on this topic:
A Rare Case of Purulent Methicillin-Resistant Staphylococcus Aureus Pericarditis Presenting with Septic Shock
Elisarraras Francisco, Roberts Jacob, Hindosh Ziad, Arega Enat, Madnick David, Cruz Daniel, Srivastava Pratyaksh
Age-, Sex- and/or Ethnic- specific disparities; Biventricular systolic and diastolic strain, and biomarker, prognostic implications in Acute Tuberculous Pericarditis.Matshela Mamotabo